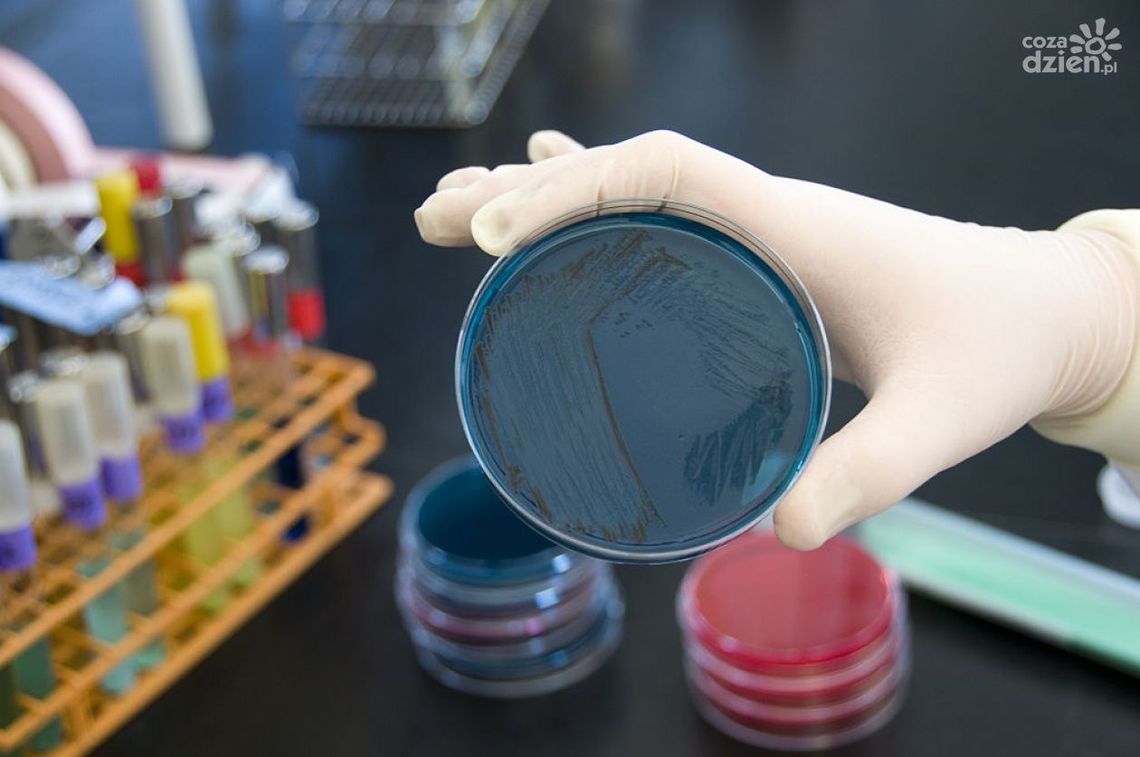
Ostrowiec Św. Obraduje sztab kryzysowy Ostrowiec Św. Obraduje sztab kryzysowy

Jak informowaliśmy, do 25 marca br. funkcjonowanie szkół, przedszkoli i innych instytucji oświatowych zostaje czasowo ograniczone. Oznacza to, że w tym okresie przedszkola, szkoły i placówki oświatowe zarówno publiczne, jak i niepubliczne nie będą prowadziły zajęć dydaktyczno-wychowawczych. To dzisiejsza decyzja Ministra Edukacji Narodowej wynikająca z konieczności zapobiegania rozprzestrzenianiu się koronawirusa. Prezydent Ostrowca Św., Jarosław Górczyńki nie ukrywa, że to przed samorządami trudne zadanie.
- Jest to zadanie bardzo trudne. W tej chwili mamy zwołane narady koordynacyjne i w mieście i w powiecie. Mamy dwa dni na przygotowanie się, aby od poniedziałku nasze placówki oświatowe były zamknięte.
Lekarze, specjaliści, eksperci WHO wskazują, że wprowadzenie takich działań może ograniczyć rozprzestrzenianie się wirusa. Obecna sytuacja epidemiologiczna w Polsce może zagrozić zdrowiu obywateli. Imprezy masowe zostają odwołane, od jutra muzea, teatry i instytucje kultury będą zamknięte. Prezydent Górczyński apeluje do mieszkańców o rozsądek i spokój.
- Apeluje o rozsądek , o to abyśmy nie ulegali emocjom. Zachowajmy spokój i wsłuchujmy się w komunikaty. Panika to najgorszy doradca i nikomu i niczemu nie służy.
Na dzisiejszym spotkaniu zostaną ustalone działania w powiecie i w mieście na najbliższe dni. Oprócz władz obecni będą dyrektorzy szkół i placówek podległych miastu i powiatowi.
Więcej o decyzjach władz już wkrótce.

Napisz komentarz
Komentarze